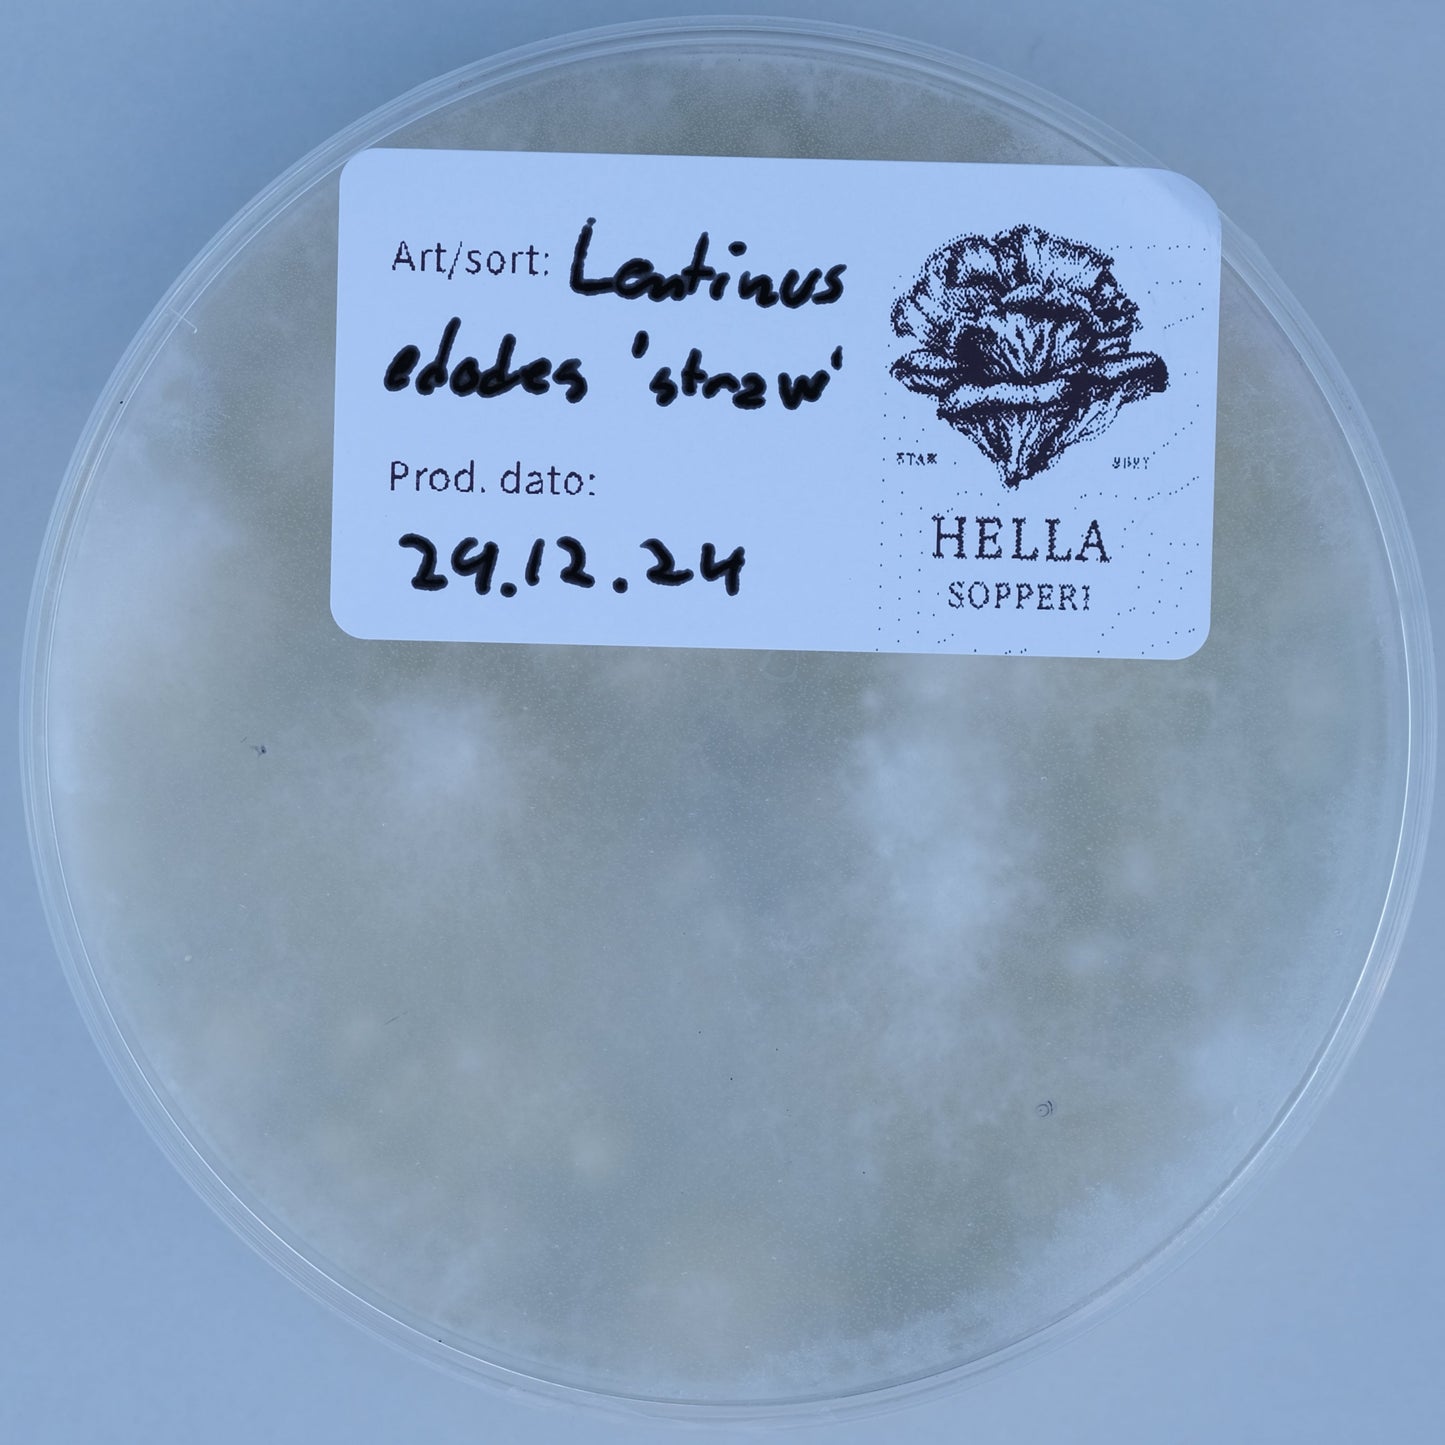

1
/
av
1
Lentinus edodes var. 'straw'
Lentinus edodes var. 'straw'
Vanlig pris
300,00 NOK
Vanlig pris
Salgspris
300,00 NOK
Enhetspris
/
per
Inkludert avgifter.
Kunne ikke laste inn hentetilgjengelighet
Dyrket på MEA-agar i 90mm petri.
Vi fornyer jevnlig våre kulturer, og handler kun fra anerkjente leverandører.